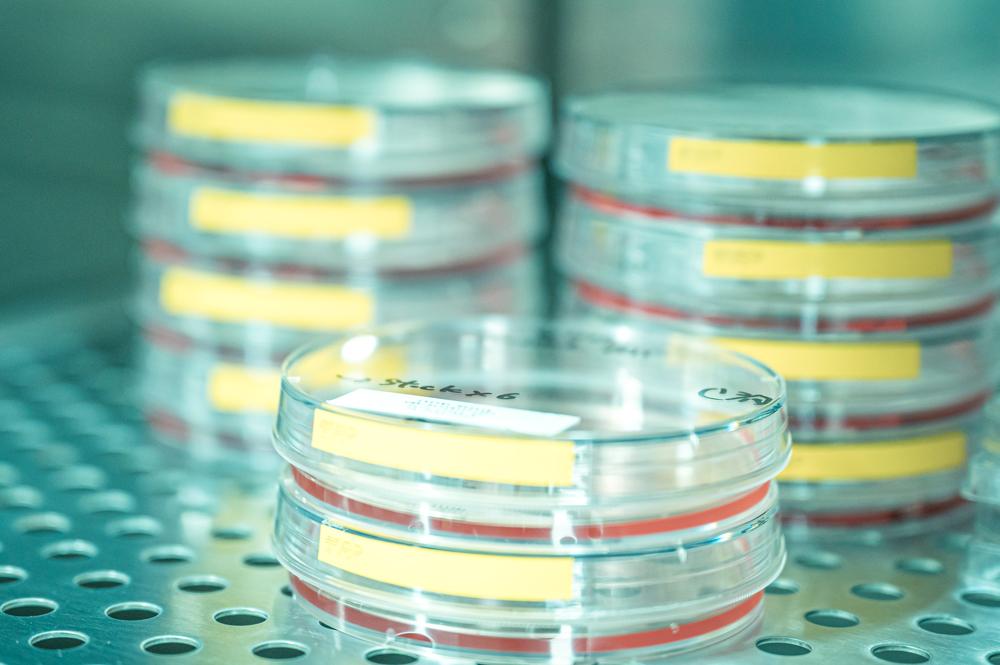

事業名
オーキシンデグロン細胞株作成支援
チーム
培養細胞チーム
担当職員
鐘巻将人、坂本佐知子
受託業務の内容
鐘巻研究室が開発したオーキシンデグロン法を利用して、標的タンパク質を分解誘導できる培養細胞株の作成を支援します。また、鐘巻研究室が論文公表した細胞株を配布します。
具体的には、培養細胞の標的遺伝子のNもしくはC末端コード領域を切断し、デグロンタグを挿入することで融合タンパク質を発現するように改変します。デグロンタグを付加した標的タンパク質は分解誘導リガンド(5-Ph-IAA)添加により、数十分から数時間といった短時間において分解除去できます。本技術はタンパク質除去の迅速性および可逆性から、世界中で先端的な生命科学研究で利用が進んでおり、従来から利用されてきたsiRNAによるタンパク質除去では研究できなかった解析が可能になります。すでに作成、論文公表したオーキシンデグロン細胞株はこれまで世界中から多数のリクエストを受けており、今後も多数の配布が見込まれています。
基本費用(大学・公的研究機関向け価格を掲載、企業向け価格は要相談)
- 細胞作成支援:5-10万円(支援内容による)(税込)
- 細胞配布:1万円/細胞株(送料別)(税込)
